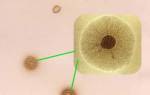

Услуги инфекционной клиники
Диагностика, профилактика и лечение
Фиброэластометрия и ультразвуковая диагностика молочных желез, щитовидной железы, мошонки, брюшной полости
Биохимия. Анализ крови: общий, клинический. Анализы на витамины, микроэлементы и электролиты. Анализ на ВИЧ-инфекцию, вирусный гепатит, бактерии, грибки и паразиты
Максимально точное определение степени фиброза печени неинвазивным методом с помощью аппарата FibroScan 502 TOUCH
Гинеколог H-Сlinic решает широкий спектр задач в области женского здоровья. Это специалист, которому можно полностью доверять
H-Сlinic dermatovenerology — это самый современный и эффективный алгоритм диагностики и лечения заболеваний, передающихся половым путем, грибковых и вирусных поражений, а также удаления доброкачественных невусов, бородавок, бородавок и папиллом
Возможности вакцинации намного шире, чем возможности Национальной программы вакцинации. H-Clinic предлагает разработку высококачественных современных планов вакцинации и вакцин на складе
Терапевт H-Сlinic эффективно решает проблемы лечения заболеваний, которые часто могут стать большой проблемой при наличии хронического инфекционного заболевания
Кардиолог H-Сlinic проведет полную диагностику сердечно-сосудистой системы и при необходимости назначит эффективную терапию. Сердечно-сосудистые проблемы при инфекционных заболеваниях требуют особых подходов, которые мы можем предложить
Наша цель — новое качество вашей жизни. Мы используем современные алгоритмы диагностики и строго соблюдаем самые эффективные протоколы лечения.
Общая терапия, Инфекционные болезни, Гастроэнтерология, Дерматовенерология, Гинекология, Вакцинация, УЗИ и фиброэластометрия, Кардиология, Неврология
Биохимия, общий / клинический анализ крови, витамины и микроэлементы / электролиты в крови, ВИЧ-инфекция, вирусный гепатит, другие инфекции, бактерии, грибы и паразиты, комплексы и тестовые пакеты со скидкой
Доступны и изготавливаются под заказ экономичные решения и высококачественные лекарства у лидеров рынка лечения инфекционных заболеваний. Аптека H-Clinic готова гибко реагировать на запросы наших клиентов. Помогаем со своевременным поиском лекарств, которых обычно нет в сети.
Клиника, диагностика и лечение токсоплазмоза
Токсоплазмоз — широко распространенная зоонозная паразитарная инфекция, характеризующаяся полиморфизмом клинических проявлений и значительной вариабельностью в ходе процесса: от здорового и бессимптомного до тяжелого протекания
Токсоплазмоз — широко распространенная зоонозная паразитарная инфекция, характеризующаяся полиморфизмом клинических проявлений и значительной вариабельностью течения процесса: от здорового и бессимптомного носительства до тяжелых и летальных форм заболевания.
Этиология
Возбудитель токсоплазмоза Toxoplasma gondii принадлежит к типу Protozoa, подтипу Sporozoa и отряду Eucoccidia. T.gondii — внутриклеточный паразит размером 4-7 мкм.
В организме человека T.gondii может паразитировать в виде пролиферативных форм — эндозитов, в виде псевдокист и в виде истинных тканевых кист. У кошек и других представителей семейства кошачьих токсоплазмоз также может присутствовать в кишечнике в виде ооцист, которые после выделения с калом во внешнюю среду сохраняют свою жизнеспособность и инвазивность в течение 1,5-2 лет. Цисты токсоплазмы, обнаруженные в мясе и мясных продуктах, могут выдерживать температуру 2–5 ° C до месяца, но быстро умирают при приготовлении или замораживании при –20 ° C. Эндозиты наименее устойчивы к факторам окружающей среды, которые остаются жизнеспособными вне организма от 30 минут до нескольких часов.
Эпидемиология
Токсоплазмы или следы их присутствия были обнаружены у более чем 200 видов млекопитающих и 100 видов птиц. Распространенность или инфицирование токсоплазмами среди населения Российской Федерации в среднем составляет около 20,0%. Уровень заболеваемости наиболее высок в регионах с теплым климатом; среди людей ряда профессиональных групп (эпидемиологические наблюдения показали повышенное инфицирование и заболеваемость токсоплазмозом у лиц, имеющих профессиональный контакт с источниками токсоплазмозной инфекции (рабочие мясокомбинатов и ферм пушных зверей, животноводы, ветеринары и др.)) Зараженность женщин, как правило, в 2-3 раза выше, чем у мужчин.
Заболеваемость токсоплазмозом в несколько раз ниже показателей инфицирования, однако трудности диагностики, несмотря на обязательную регистрацию, не позволяют судить об истинном уровне заражения.
Восприимчивость к токсоплазмозу почти универсальна. Инфекция распространяется повсеместно в виде транспортных и спорадических заболеваний.
Основным источником заражения при токсоплазмозе являются бездомные кошки, дикие и домашние, в организме которых возбудитель проходит полный цикл развития (тканевый и кишечный) и выводится в виде ооцист с их фекалиями. Кошки теряют патоген в среднем до трех недель после заражения. За этот период в окружающую среду попадает до 1,5 миллиарда токсоплазм.
Основной фактор передачи — сырое или недостаточно термически обработанное мясо, мясные продукты с цистами токсоплазмы в них. К дополнительным факторам передачи инфекции относятся плохо вымытые овощи, зелень, фрукты (из земли), грязные руки с ооцистами возбудителей болезней на них.
Основной и наиболее частый путь передачи инфекции — оральный, гораздо реже инфицирование человека может осуществляться трансплацентарным (переливание крови), чрескожным и трансплантатным.
Больной токсоплазмозом не представляет эпидемиологической опасности ни для окружающих, ни для медицинского персонала, что дает возможность лечить этих пациентов как амбулаторно, так и в любом соматическом стационаре.
Иммунитет. Иммунитет при токсоплазмозе нестерильный, заразный. Иммунное состояние организма сохраняется одновременно с наличием в организме возбудителя, чаще всего в виде кисты. Антигенные метаболиты, продуцируемые цистами, поддерживают определенный уровень гуморального иммунитета, а также вызывают развитие гиперчувствительности замедленного типа.
Патогенез
Патогенные микроорганизмы, выделяемые кистами или ооцистами, проникают в эпителиальные клетки тонкой кишки, где они размножаются, формируя первичный аффект, а затем проникают в регионарные лимфатические узлы, а из них с током лимфы в кровь. Распространение возбудителя приводит к повреждению самых разных органов и тканей.
Токсоплазмы оказывают на клетку цитопатогенное действие, а в местах их внедрения образуются воспалительные гранулемы. Развивается некроз, в месте выпадения известковых солей образуются характерные для токсоплазмоза обызвествления. Степень поражения того или иного органа в дальнейшем определяет клинические симптомы заболевания.
Формирование иммунитета приводит к исчезновению возбудителя из крови, а его размножение в клетках прекращается. Формируются настоящие тканевые кисты, которые могут сохраняться в организме длительное время, десятилетиями, в неповрежденном состоянии (носительство токсоплазмы). У человека инфекция обычно протекает доброкачественно, без развития септических состояний.
Клиника
У большинства инфицированных клинических проявлений заболевания нет. В подавляющем большинстве случаев при токсоплазмозе наблюдается здоровый транспорт паразита, сопровождающийся постоянно низким уровнем специфических антител в крови. Транспортировка не требует каких-либо лечебных мероприятий, и пользователь должен считаться практически здоровым человеком.
При этом возможны и клинически выраженные варианты течения инфекции, требующие тщательной диагностики и специфического лечения.
Приобретенный токсоплазмоз по характеру течения делится на острый и хронический. Кроме того, в зависимости от длительности заболевания и выраженности клинических симптомов возможно подострое и неявное (субклиническое) течение, характеризующееся определенной динамикой или высоким уровнем специфических антител в крови, при отсутствии клинических проявлений болезни. Поэтому наиболее удобной для практического здравоохранения, с нашей точки зрения, является следующая классификация приобретенного токсоплазмоза: острый, подострый, хронический, незаметный и носительский.
Инкубационный период токсоплазмоза длится в среднем до 2 недель, хотя иногда может длиться до нескольких месяцев. Заболевание, как правило, начинается постепенно: появляется общая слабость, недомогание, мышечные боли, озноб, снижение работоспособности, повышается температура до субфебрильных цифр. Увеличиваются лимфатические узлы: шейные, затылочные, реже подмышечные и паховые. Лимфатические узлы мягкие, при пальпации слегка болезненны. Размер узлов 1-1,5 см, они не срастаются с окружающими тканями, не образуют конгломератов, кожа над ними не изменена. Иногда брыжеечные лимфатические узлы значительно увеличены, что может имитировать изображение острого живота.
Гораздо реже встречается острое начало, с повышением температуры до 38 ° С и выше с вовлечением в процесс, помимо лимфатической, нервной системы, внутренних органов, мышечной ткани, органов зрения. У больных могут развиться энцефалит, миокардит, миозит, увеит (хориоретинит). В некоторых случаях возникает кратковременная розеоло-папулезная сыпь, гепатолиенальный синдром. У пациентов с иммунологическими нарушениями (особенно со СПИДом) может развиться пневмония, энтероколит, тяжелые кистозно-некротические нарушения ЦНС и септическое состояние.
Хронический токсоплазмоз — длительно протекающий процесс с общим инфекционным синдромом и наличием поражений органов разной степени тяжести. Наиболее характерными признаками хронического токсоплазмоза являются длительная субфебрильная температура, интоксикация и астения, лихорадка может длиться месяцами, с небольшими перепадами температуры, иногда с короткими периодами апирексии, не поддающимися традиционной терапии. Распространенное проявление токсоплазмоза — генерализованное увеличение лимфатических узлов: затылочных, шейных, паховых и других.
Поражение центральной нервной системы при хроническом токсоплазмозе чаще всего протекает в виде базального церебрального арахноидита; Развиваются гипертонический и диэнцефальный синдромы, возникают вегето-сосудистые нарушения и отмечается эпизод. Возможны замедленный миокардит, дистрофия миокарда и миозит. У женщин могут быть специфические воспалительные заболевания половых органов — токсоплазменный сальпингоофорит (аднексит); для формирования первичного и вторичного бесплодия.
Поражение глаз как при остром, так и при хроническом приобретенном токсоплазмозе протекает как задний увеит (очаговый хориоретинит). Хориоретинит обычно бывает центральным, двусторонним, рецидивирующим. Возможно развитие конъюнктивита, кератита, иридоциклита, центрального экссудативного ретинита, неврита зрительного нерва с дистрофическим исходом, осложненной миопии.
Рентгенологическое исследование больного токсоплазмозом позволяет в некоторых случаях выявить наличие кальцификатов в мягких тканях головного мозга. Кальцификации обычно мелкие, множественные, округлые, часто с ровными очертаниями.
Как при остром, так и при хроническом токсоплазмозе специфических изменений периферической крови нет. Лейкоцитоз, наблюдаемый в начале заболевания, сменяется нормоцитозом, выявляется относительный лимфоцитоз, СОЭ в пределах нормы.
Следует подчеркнуть, что при хроническом токсоплазмозе нет изолированного поражения какого-либо органа или системы, можно говорить о преимущественном поражении органа на фоне общего процесса.
Диагностика
Дифференциальная диагностика. Токсоплазмоз необходимо дифференцировать от инфекционного мононуклеоза, доброкачественного лимфоретикулеза, туберкулеза, бруцеллеза, листериоза, микоплазмоза, хламидиоза, цитомегалии, герпеса и ряда других бактериальных, вирусных и паразитарных инфекций. Следует исключить рак и системные заболевания (например: лимфогранулематоз, ревматизм и т.д.).
Лабораторная диагностика. Для лабораторной диагностики токсоплазмоза часто используются серологические методы: реакция связывания комплемента (CSC), реакция непрямой иммунофлуоресценции (RNIF) и иммуноферментный тест (ELISA). Диагноз подтверждается достоверным увеличением динамики показателей этих тестов, их высоким уровнем или наличием антител класса IgM.
При клинической оценке результатов серологического обследования пациента следует иметь в виду, что RNIF становится положительным с первой недели заболевания и достигает максимальных значений (1: 1280-1: 5000), как правило ко второму или четвертому месяцу болезни низкие титры могут сохраняться от одного года до 15 лет. RSC становится положительным со второй недели заболевания, достигает максимальных значений (1: 160-1: 320) к второму-четвертому месяцу заболевания, но через 2-3 года может исчезнуть или снизиться до значений of 1: 5-1: 10. Интерпретация результатов ELISA более объективна, поскольку она ориентирована на международный стандарт ВОЗ. Положительные результаты могут быть отмечены показателями, выраженными в оптических единицах оптической плотности (OD ≥1,5); блок иммуноферментного анализа (EIU) ≥60; Международные единицы (МЕ) ≥125 и в титрах антител (ТА) ≥1: 1600. К этому методу применим и основной принцип серологической диагностики — динамика роста показателей. Большое значение в диагностике токсоплазмоза, особенно при дифференциации острых и хронических процессов, имеет определение классов иммуноглобулинов, в частности антител класса IgM. Достоверно диагностировать токсоплазменную инфекцию можно, только сравнив результаты серологических реакций в динамике. Антитела всех классов значительно увеличиваются к концу второй — началу третьей недели с момента заражения и достигают диагностического уровня.
Диагноз токсоплазмоза, если он доступен клинически, может быть поставлен с положительной конверсией сыворотки, когда второй анализ сыворотки положителен. При лечении пациентов с уже установленными положительными реакциями на токсоплазмоз вопрос диагностики, активности инфекционного процесса может решаться в динамике серологических исследований. При новой инфекции и заболевании серологические реакции часто оказываются положительными по высоким титрам антител, выявляются специфические IgM. При реактивации латентного токсоплазмоза возможно повышение концентрации IgM, но в этом случае выраженность ответа IgM будет намного меньше, чем в случае первичной инфекции. Положительный RNIF при низком титре может указывать на хронический токсоплазмоз или бессимптомное носительство возбудителя. Следует отметить, что при глазной патологии наличие нового очага воспаления даже при низких титрах антител свидетельствует о токсоплазмозе. При лимфаденопатиях даже при высоких титрах антител диагноз токсоплазмоза ставится только после гистологического исследования лимфатических узлов и консультации онколога. По результатам единичного исследования невозможно установить длительность инфекционного процесса и точное соответствие той или иной его стадии, в то время как для оценки риска внутриутробного инфицирования плода эта проблема является принципиальной. Женщины, перенесшие инфекцию до зачатия, и женщины с хроническим токсоплазмозом практически застрахованы от риска внутриутробного инфицирования плода, в то время как беременные, инфицированные в первом и начале второго триместра беременности, составляют основную группу риска. Однако следует помнить, что обнаружение и подтверждение наличия антител IgM не является единственным показателем выкидыша. Следует использовать дополнительные методы, чтобы снизить риск постановки неточного диагноза.
Формирование диагноза. При формировании развернутого диагноза токсоплазмоз необходимо указать следующее:
Например: острый приобретенный токсоплазмоз, лимфаденопатия, легкое течение; хронический приобретенный токсоплазмоз с преимущественным поражением глаз, хориоретинит без обострения; беременность 24-26 недель, токсоплазмоз незаметный.
При постановке диагноза токсоплазмоз только на системную или органную патологию (лимфаденопатическую, церебральную, миокардит, глазную форму и т.д.) нецелесообразно, поскольку токсоплазмоз следует рассматривать как общий процесс, затрагивающий многие органы и системы.
Если токсоплазмоз исключен и пациенту с положительной реакцией на токсоплазмоз выставлен другой диагноз, в анамнезе также следует отметить существующий транспорт токсоплазмы.
Уход
Выбор лечебной тактики зависит от формы и характера течения заболевания, выраженности клинических симптомов, тяжести течения, наличия осложнений и преобладающих органо-системных поражений.
Абсолютными показаниями к назначению лечения являются острый и подострый токсоплазмоз. Лечение хронического токсоплазмоза проводится исходя из выраженности клинических симптомов, характера преобладающих поражений. Невыявленный токсоплазмоз, диагностированный у беременных, также требует лечения.
Прописаны препараты «Фансидар», «Ровамицин» и «Бисептол». Фансидар содержит 500 мг сульфадоксина и 25 мг пириметамина. Этиотропная терапия состоит из 2-3 циклов. Назначают по 1 таблетке 1 раз в 3 дня (8 таблеток). Фолиевая кислота назначается между курсами. При непереносимости препаратов группы пириметамина назначают Ровамицин, из которых в 1 таблетке содержится 3 млн МЕ спиромицина. Назначают по 3 млн МЕ 3 раза в сутки с семидневным перерывом. Хорошая переносимость Ровамицина пациентами, отсутствие лекарственных взаимодействий и высокая эффективность позволяют назначать его для лечения токсоплазмоза во всех возрастных группах.
Возможно применение комбинированных препаратов; Потесептила (триметоприм + сульфадимезин), Бисептол (триметоприм + сульфаметоксазол), которые назначают по 1 таблетке 2 раза в день в течение 10 дней (цикл), в количестве 2-3 циклов (курс). При непереносимости этих препаратов при пероральном приеме возможно назначение Бисептола внутривенно или капельно: 10 мл в сутки, в течение 5 дней (курсом). В перерывах между курсами (курсами) этиотропной терапии назначают фолиевую кислоту в среднем до 0,01 г в сутки.
В случае выявления состояния иммунодефицита наряду с этиотропной терапией назначают иммунотропные средства: Ликопид, Циклоферон, Витамедин-М, а также натуральные гормоны вилочковой железы телят и их синтетические аналоги: Тактивин, Тимамин, Тимоген, Декарис.
Препараты для системной энзимотерапии (СЭТ), в частности Вобэнзим и Флогензим, также используются в комплексной терапии. Для сохранения микробиоценоза кишечника рекомендуется назначение пробиотиков и пребиотиков.
Лечение и дальнейшее наблюдение в диспансере за пациентами должны проводить специалисты в зависимости от характера преобладающей патологии — врачи-инфекционисты, невропатологи, офтальмологи, акушеры-гинекологи и др. — гинекологический, детский и тд). Это связано с особенностями патологии органа, спецификой обследования и назначением дополнительных средств лечения.
Клиническое обследование
Наблюдение в диспансере проводится врачами по профилю преобладающей патологии, в каждом конкретном случае индивидуально. После острого (неявного) токсоплазмоза пациенты проходят обследование и обследование каждые 3-4 месяца в течение года, затем 1-2 раза в год. Пациенты с хроническим токсоплазмозом консультируются 2 раза в год.
Профилактика
Профилактика приобретенного токсоплазмоза включает: употребление в пищу только хорошо обработанных мясных продуктов; устранение привычки дегустировать сырой фарш или сырое мясо; ешьте чисто промытые (оторванные от земли) овощи, зелень и фрукты; тщательное мытье рук после обработки сырого мяса, сырых мясных продуктов, после работы на огороде, в огороде, у детей — после игр на детской площадке, особенно в песочнице; бороться с бездомными кошками; лечение больных токсоплазмозом домашних кошек, профилактика заражения последних. Специфической профилактики токсоплазмоза не разработано.
Диагностика, клиника и лечение токсоплазмоза у беременных
Диагностика токсоплазмоза у беременных включает полный комплекс необходимых клинических, параклинических и специальных (иммунобиологических) исследований, используемых для диагностики токсоплазмоза в целом.
Обязательным условием для обследования беременной на токсоплазмоз должна быть консультация врача-инфекциониста для подтверждения или исключения текущего манифестного или бессимптомного (неявного) инфекционного процесса токсоплазмы. После подтверждения диагноза и необходимости лечения последнее проводится акушером-гинекологом в амбулаторных условиях (в женской консультации) или в акушерско-гинекологическом стационаре (роддоме). Учитывая эпидемиологическую безопасность больных токсоплазмозом для окружающих, беременная женщина с неосложненным акушерским анамнезом, но с диагнозом токсоплазмоз может быть госпитализирована для обследования, лечения и родов в любое (физиологическое) отделение больницы. В отделение патологии беременных поступают беременные с отягощенным акушерским анамнезом и диагнозом токсоплазмоз.
Обследование беременных на токсоплазмоз необходимо проводить в женских консультациях при первом посещении беременной. При проведении этого обследования акушер-гинеколог должен помнить, что в нашей стране в зависимости от региона процент инфицированных женщин детородного возраста составляет в среднем 20-30%, т.е каждая третья из них может положительно отреагировать на токсоплазмоз. Как правило, беременные с положительными иммунологическими реакциями являются здоровыми носителями возбудителя и не нуждаются ни в каких терапевтических, а тем более хирургических вмешательствах. У этих женщин практически нет жалоб и объективных проявлений инфекции. Уровни специфических антител остаются стабильно неизменными, как правило, низкие, специфических антител класса IgM нет. 70-80% женщин не имеют инфекций и отрицательно реагируют на токсоплазмоз. Эти женщины представляют группу «риска» по врожденному токсоплазмозу, так как 0,5–1% из них заражаются токсоплазмозом во время беременности. Из женщин, инфицированных в основном во время беременности (группа высокого «риска»), 30-40% передают инфекцию плоду. В результате наблюдение диспансера для профилактики врожденного токсоплазмоза и обследование в динамике (1 раз в 1-2 месяца) при беременности подлежат неиммунные (иммунонегативные) женщины на выявление новой инфекции.
Клинические проявления токсоплазмоза у беременных существенно не различаются. Острый токсоплазмоз сопровождается повышением температуры до фебрильных (чаще субфебрильных) цифр, выявляется лимфаденит (чаще шейный и задне-затылочный), возможны нарушения со стороны центральной нервной системы, внутренних органов, глаз и мышц. Когда женщины заражаются незадолго до беременности или на ранних сроках беременности, возможно заражение яйцеклетки токсоплазмой, что обычно приводит к выкидышу. Также акушеру-гинекологу следует помнить о возможном неявном (бессимптомном) течении острого токсоплазмоза у женщин во время беременности, когда развитие заболевания фиксируется как по достоверно возрастающей динамике уровня специфических антител, так и по выявлению иммуноглобулинов IgM в ИФА, который требует серологического контроля (скрининга) беременных женщин, не инфицированных во время беременности.
Хронический токсоплазмоз у беременных характеризуется общим инфекционным синдромом (умеренная лихорадка, генерализованная лимфаденопатия, озноб, снижение работоспособности и т.д.) н возможными преимущественными поражениями внутренних органов, глаз, центральной нервной системы и половых органов.
Показанием к назначению этиотропной антитоксоплазматической терапии беременным является острый, подострый и незаметный токсоплазмоз. Лечение хронического токсоплазмоза должно проводиться строго по клиническим показаниям до или после беременности.
При отсутствии жалоб и клинических показаний женщинам, перенесшим токсоплазмоз до беременности, лечение не требуется. Эти женщины считаются практически здоровыми людьми, не нуждающимися в особом медицинском наблюдении.
Поэтому практически актуален вопрос о сроках заражения беременной женщины: намного раньше, непосредственно до или во время беременности. Срок заражения устанавливается на основании анамнеза женщины и полного обследования (кордоцентез и амниоцентез). Лечение беременных проводить не ранее 12-16 недель беременности (со второго триместра беременности). Лечение обычно проводят Ровамицином, Фансидаром.
Ровамицин назначают в суточной дозе 3 млн 2 раза в сутки, продолжительность приема — 7 дней, количество циклов — 2, перерыв между циклами — 1 месяц.
Концентрация ровамицина в плаценте в 5 раз выше, чем в сыворотке крови, что обеспечивает излечение. Ровамицин — первый макролид, применяемый для лечения токсоплазмоза у беременных. Хорошая переносимость Ровамицина пациентами, отсутствие лекарственных взаимодействий и высокая эффективность позволяют назначать его для лечения токсоплазмоза во всех возрастных группах.
Фансидар назначают по 1 таблетке 1 раз в 3 дня (№ 8 таблеток). Перерыв между циклами — один месяц. Назначено 3 таких цикла.
Учитывая возможное угнетение кроветворения под действием этиотропных препаратов, рекомендуется назначать фолиевую кислоту в средних терапевтических дозах, а также проводить общие анализы крови и мочи.
В практической работе особое значение приобретает вопрос о показаниях к искусственному прерыванию беременности при токсоплазменной инфекции и рекомендации при последующих беременностях.
Обобщая все вышесказанное, следует подчеркнуть, что только в случае инфицирования в первом триместре беременности и при наличии клинико-иммунологических признаков острого приобретенного или неявного токсоплазмоза, когда существует риск рождения ребенка с макроскопическими органическими поражениями центральная нервная система и органы зрения крупнее, можно ставить вопрос о прерывании беременности по медицинским показаниям! Лечению подлежат женщины, заразившиеся во 2-м и 3-м триместре беременности. Прерывание беременности по медицинским показаниям и женщинам с хроническим токсоплазмозом, а тем более с носителем возбудителя, не показано, так как в этих случаях нет опасности инфицирования плода, потому что даже обострение процесса у беременных не приводят к повторным паразитемиям и, как следствие, к поражению плаценты, а через нее и плода.
Давая рекомендации для последующих беременностей, следует учитывать, что одна и та же женщина может родить ребенка с врожденным токсоплазмозом только один раз в жизни (из-за острого приобретенного или неявного токсоплазмоза во время беременности). При более поздних беременностях эта женщина может не опасаться рождения ребенка с токсоплазмозом.
Профилактика врожденного токсоплазмоза
Профилактика врожденного токсоплазмоза должна основываться на том, что только первичное инфицирование женщины во время беременности может привести к инфицированию плода. Как упоминалось выше, из общего числа неиммунных женщин во время беременности инфицированы до 1% беременных. При этом инфицированы плоды только у 30-40% из них. По данным литературы, количество новорожденных с врожденным токсоплазмозом составляет 1-8 на 1000 живых новорожденных. Чаще всего процесс у ребенка протекает бессимптомно, хотя не исключено проявление болезни в будущем. Это может происходить под влиянием иммуносупрессивных факторов в период формирования иммунитета, то есть в течение первых 5-7-10 лет жизни.
Оптимально профилактика врожденного токсоплазмоза должна включать скрининг на токсоплазмоз у женщин детородного возраста до или, в крайних случаях, во время беременности. Это обследование необходимо для выявления среди них тех, кто отрицательно реагирует на это заболевание, то есть неиммунных женщин. Последние составляют группу риска возможной первичной инфекции во время беременности.
Беременных, не имеющих иммунитета, следует брать для наблюдения в диспансер и обследовать на токсоплазмоз, но с помощью серологических тестов (RSK, RNIF, ELISA и др.) На протяжении всей беременности, по возможности, один раз в 1-2 месяца или во время беременности не реже 1 раза в квартал.
При переходе у беременных из группы «риска» отрицательных серологических реакций в положительные и выявлении нарастающей в 3-4 раза динамики уровня специфических антител им требуется экстренное профилактическое лечение. Лечение проводится как при явном течении инфекции, так и в случае протекания процесса в аппарате. Дети, рожденные этими женщинами, подлежат обязательному клиническому и серологическому обследованию на токсоплазмоз и, по показаниям, специальному лечению. Для детей, рожденных от матерей с установленной первичной инфекцией во время беременности, устанавливается диспансерное наблюдение до 10 лет, включая регулярные клинические и иммунологические осмотры, с целью выявления симптомов врожденного токсоплазмоза, который может протекать бессимптомно при рождении.
При условии, что при последнем обследовании беременных группы «риска» серологические реакции остаются отрицательными, женщинам (без клинических показаний) не требуется дополнительных специальных обследований на токсоплазмоз и после родов они отказываются от наблюдения. Младенцы, рожденные этими женщинами, должны проходить скрининг на токсоплазмоз только при наличии клинических показаний. Беременным с отрицательными иммунологическими реакциями рекомендуется строго соблюдать основные правила профилактики токсоплазмоза.
Литература
Ф.К. Дзуцева, врач высшей категории, заведующий городским центром токсоплазмоза Г.Ю. Никитин, кандидат медицинских наук Ю. В. Борисенко, кандидат медицинских наук Л.П. Иванова *, кандидат медицинских наук, доцент ГКБ им. С.П. Боткина, * РМАПО, г. Москва